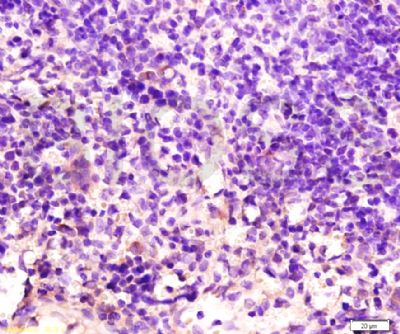
产品细节图片6

万千商家帮你免费找货
0 人在求购买到急需产品
- 详细信息
- 文献和实验
- 技术资料
- 免疫原:
KLH conjugated
- 亚型:
IgG
- 形态:
冻干粉
- 保存条件:
Store at -20 °C for one year
- 克隆性:
多克隆
- 标记物:
见说明书
- 适应物种:
见说明书
- 宿主:
Rabbit
- 应用范围:
WB=1:500-2000 ELISA=1:500-1000 IHC-P=1:400-800 IHC-F=1:400-800 IF=1:100-500
- 浓度:
1mg/ml
- 靶点:
见说明书
- 抗体英文名:
SCF
- 抗体名:
干细胞生长因子免疫组化荧光抗体
- 规格:
100ul
中文名称干细胞生长因子抗体
别 名Stem Cell Factor; C kit ligand; Ckit ligand; DKFZp686F2250; KIT ligand; Kitl; KITLG; KL 1; KL1; Mast cell growth factor; MGF; SF; SHEP7; Steel factor; Stem cell factor precursor; SCF_HUMAN.
文献引用
规格50ul 100ul 200ul
研究领域细胞生物 干细胞 生长因子和激素 细胞膜蛋白
抗体来源Rabbit
克隆类型Polyclonal
交叉反应 Human, Mouse, Rat,
产品应用WB=1:500-2000 ELISA=1:500-1000 IHC-P=1:400-800 IHC-F=1:400-800 Flow-Cyt=1ug/Test IF=1:100-500 (石蜡切片需做抗原修复)
not yet tested in other applications.
optimal dilutions/concentrations should be determined by the end user.
分 子 量31kDa
细胞定位细胞浆 细胞膜 分泌型蛋白
性 状Lyophilized or Liquid
浓 度1mg/ml
免 疫 原KLH conjugated synthetic peptide derived from human SCF C-terminus:
亚 型IgG
纯化方法affinity purified by Protein A
储 存 液0.01M TBS(pH7.4) with 1% BSA, 0.03% Proclin300 and 50% Glycerol.
保存条件Store at -20 °C for one year. Avoid repeated freeze/thaw cycles. The lyophilized antibody is stable at room temperature for at least one month and for greater than a year when kept at -20°C. When reconstituted in sterile pH 7.4 0.01M PBS or diluent of antibody the antibody is stable for at least two weeks at 2-4 °C.
PubMedPubMed
产品介绍background:
Stem Cell Factor (SCF), also known as c-Kit ligand (KL), steel factor (SLF) and mast cell growth factor (MGF), is a 30 kDa glycoprotein with broad activities on various tissues, including hematopoietic cells, pigment cells, and primordial germ cells. SCF is secreted by endothelial cells, fibroblasts, and bone marrow stromal cells as a membrane-bound form which may be cleaved to release the soluble form. Both forms are active in promoting colony formation from murine bone marrow cells, but membrane-bound SCF is more effective in promoting hematopoieses in vivo, suggesting a role in cellular interactions between hematopoietic and stromal cells. The soluble form is thought to exist in solution as a noncovalently linked dimer. SCF is structurally related to M-CSF (CSF-1) and Flt-3/Flk-2 Ligand (FL) with all three sharing a similar size, existence of transmembrane and soluble forms, four conserved cysteines, and alternative splicing exon locations, but they share little sequence homology. SCF alone is a modest colony stimulating factor. However, in the presence of other cytokines such as EPO, TPO, GM-CSF, G-CSF, M-CSF, IL-3, and IL-7, SCF is a potent costimulant that works synergistically to increase the size of myeloid, erythroid or lymphoid lineage colonies without influencing the lineage differentiation of the progenitors.
Subunit:
Homodimer, non-covalently linked (Probable). Heterotetramer with KIT, binding two KIT molecules; thereby mediates KIT dimerization and subsequent activation by autophosphorylation.
Subcellular Location:
Isoform 1: Cell membrane; Single-pass type I membrane protein. Isoform 2: Cell membrane; Single-pass type I membrane protein. Cytoplasm, cytoskeleton. Soluble KIT ligand: Secreted.
Similarity:
Belongs to the SCF family.
SWISS:
P21583
Gene ID:
4254
Database links:
Entrez Gene: 4254 Human
Omim: 184745 Human
SwissProt: P21583 Human
Unigene: 1048 Human
Important Note:
This product as supplied is intended for research use only, not for use in human, therapeutic or diagnostic applications.
Stem Cell Factor(SCF,又称Kit ligand=KITLG)—干细胞生长因子。是c-kit的配体。有膜结合型和可溶型两种存在形式。具有多向性的促生长作用。
风险提示:丁香通仅作为第三方平台,为商家信息发布提供平台空间。用户咨询产品时请注意保护个人信息及财产安全,合理判断,谨慎选购商品,商家和用户对交易行为负责。对于医疗器械类产品,请先查证核实企业经营资质和医疗器械产品注册证情况。
文献和实验未分化状态,尽管所有必需的生长因子都存在。 Reubinoff的研究团队正在研究hESC簇分化成神经细胞,他们一直在使用Invitrogen的Neurobasal培养基。这种培养基能够在无滋养层的条件下长时间维持神经细胞的生长和正常表型。在研究过程中,研究人员注意到并非所有细胞都分化了。他们怀疑是培养基的选择导致了这种现象,于是他们开始集中精力研究培养基如何促进干细胞生长并抑制分化。 为了验证他们的理论,研究小组定制了培养基。他们在Neurobasal培养基中加入了血清替代物,还加入了干细胞生长
今天发表在BMC医学杂志上的一项研究报告首次表明,血小板来源的生长因子通过招募间充质干细胞与骨折修复有关。在这篇客座文章中,共同作者Peter Giannoudis、Hiang Boon Tan和Elena Jones解释了这项研究。人们对利用干细胞重建因创伤或疾病而受损的组织和器官越来越感兴趣。干细胞是形成这些组织的成熟细胞的前身,可以在特定的化学和生物力学因素的驱动下形成成熟细胞和细胞外基质,从而形成模仿天然组织的替代组织。在过去的10 - 20年,重大的科学技术的开发和工业的努力一直集中
上海西唐生物科技有限公司 021-55229872, 65333639 www.westang.com 大鼠干细胞生长因子 (SCF)ELISA 试剂盒 ( 用于血清、血浆、细胞培养上清液和其它生物体液内 ) 原理 本实验采用双抗体夹心 ABC-ELISA 法。用抗大鼠 SCF 单抗包被于酶标板上,标准品和样品中的 SCF 与单抗结合,加入生物素化的抗大鼠 SCF ,形成免疫复合物连接在板上,辣根
技术资料暂无技术资料 索取技术资料